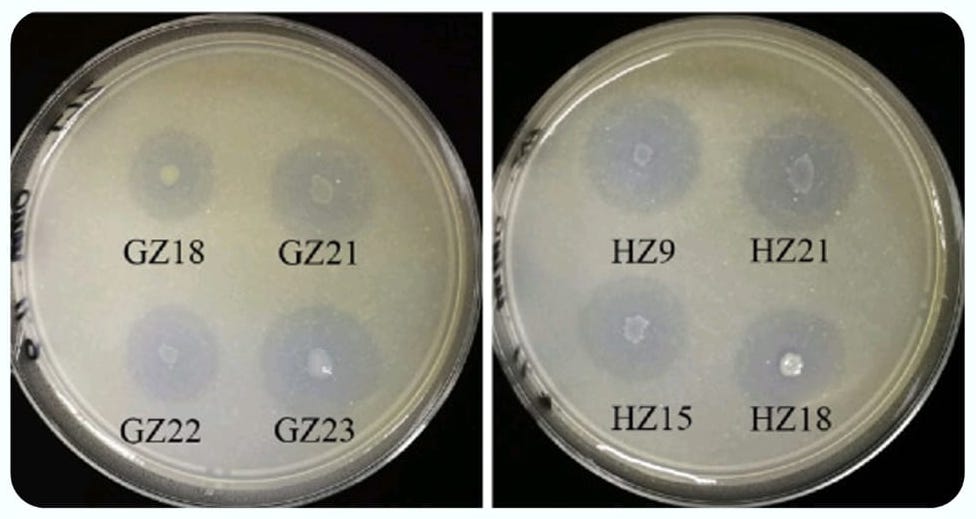
Potassium Solubilizing Bacteria

.::.
Potassium Solubilizing Bacteria
.::.
----------------
Agricultural productivity worldwide faces significant challenges due to potassium deficiency, despite soils containing substantial reserves of total potassium. Approximately 90-98% of soil potassium exists in insoluble forms that plants cannot directly absorb, creating a critical limitation in crop nutrition. Conventional agriculture depends heavily on synthetic potassium fertilizers to address this deficiency, but these fertilizers are expensive, environmentally problematic, and derived from finite potash reserves concentrated in only a few geographical regions. The excessive use of potassium fertilizers contributes to soil salinity, nutrient imbalances, and environmental degradation through runoff. Potassium Solubilizing Bacteria (KSB) have emerged as a sustainable biotechnological solution that mobilizes soil-bound potassium while reducing dependence on synthetic fertilizers and minimizing environmental impact.

